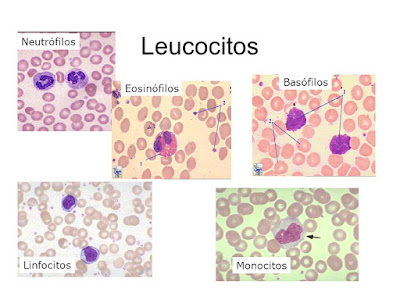

La dinámica de poblaciones es la especialidad de la ecología que se ocupa del estudio de los cambios que sufren las poblaciones biológicas en cuanto a tamaño, dimensiones físicas de sus miembros, estructura de edad y sexo y otros parámetros que las definen, así como de los factores que causan esos cambios y los mecanismos por los que se producen.
La dinámica de poblaciones es el principal objeto de la biología matemática en general y de la ecología de poblaciones en particular. Tiene gran importancia en la gestión de los recursos biológicos, como las pesquerías, en la evaluación de las consecuencias ambientales de las acciones humanas y también en campos de la investigación médica relacionados con las infecciones y la dinámica de las poblaciones celulares.

Crecimiento
Todas las especies biológicas están concentradas en producir mayor número de descendientes que los necesarios para mantener el tamaño de la población. Este es un principio fundamental para el concepto de selección natural con que el Darwinismo explica la evolución biológica en su aspecto mecanístico. En ausencia de limitaciones impuestas por el medio, el destino natural de una población es su crecimiento exponencial, tal como explicó, hace casi dos siglos, Robert Malthus. En la práctica, el crecimiento de la densidad de la población hace aparecer obstáculos a su continuidad, relacionados esencialmente con la progresiva escasez de recursos que provoca, a la vez que pone en marcha mecanismos intrínsecos de control del crecimiento.
El crecimiento poblacional es un fenómeno biológico y natural que está íntimamente ligado con aquella característica principal de la materia viva conocida como la capacidad reproductiva de los seres vivos. Es decir, el hecho de que una población llegue, con el tiempo, a saturar una determinada área geográfica, además de haber agotado todos los recursos que éste le pueda brindar, no es otra cosa que la manifestación de la ley natural. La ley natural de la vida que determina la existencia de las cosas. Podemos definir entonces, apoyados en la ley natural de la vida, tres fases en el crecimiento poblacional: El Inicio o Fase de Asentamiento, El intervalo de Abundancia o Fase de Desarrollo y La Decadencia o Fase de Control...

Fase de asentamiento
Comprendido como el punto de partida del crecimiento poblacional, en ésta fase encontramos a una población vulnerable, es decir, la población se enfrenta a las condiciones favorables o desfavorables que el medio (desconocido) le ofrece, pudiendo adaptarse o no a dichas condiciones, entonces, la adaptación de la población será un factor gravitante en esta primera fase. Las consecuencias de la incapacidad de adaptación que presente la población pueden manifestarse de dos maneras: La extinción de la especie o la migración definitiva de la población. Ahora, si es que la población logra adaptarse, estaríamos hablando de la Fase de Asentamiento propiamente dicha.
En el proceso de adaptación se produce la muerte de aquellos individuos que no presentan las condiciones adecuadas para enfrentarse a las adversidades del nuevo medio, es decir, se da el proceso de la selección natural. Entonces, al terminar esta fase encontraremos individuos adaptados

 Gráficamente se trata de un doble histograma de frecuencias. Las barras del doble histograma se disponen en forma horizontal, es decir, sobre la línea de las abscisas, y convencionalmente se indican los grupos de edad de la población masculina a la izquierda y los que representan la población femenina a la derecha. A su vez, en el eje de las ordenadas se disponen e identifican los grupos de edad, por lo general, de cuatro en cuatro años (0 a 4, 5 a 9, 10 a 14, etc.), colocando las barras de menor edad en la parte inferior del gráfico y aumentando progresivamente hacia la cúspide las edades de cada intervalo.
Gráficamente se trata de un doble histograma de frecuencias. Las barras del doble histograma se disponen en forma horizontal, es decir, sobre la línea de las abscisas, y convencionalmente se indican los grupos de edad de la población masculina a la izquierda y los que representan la población femenina a la derecha. A su vez, en el eje de las ordenadas se disponen e identifican los grupos de edad, por lo general, de cuatro en cuatro años (0 a 4, 5 a 9, 10 a 14, etc.), colocando las barras de menor edad en la parte inferior del gráfico y aumentando progresivamente hacia la cúspide las edades de cada intervalo..png)